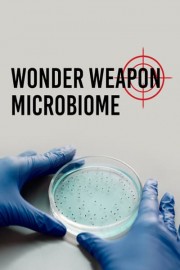
Wonder Weapon Microbiome

Watch Wonder Weapon Microbiome
- 2021
- 45 min
In recent years more and more details about the enormous health significance of the microbiome, i.e. the bacterial colonization of our body, have been uncovered - with amazing health implications.
Wonder Weapon Microbiome is a 2021 documentary with a runtime of 45 minutes.